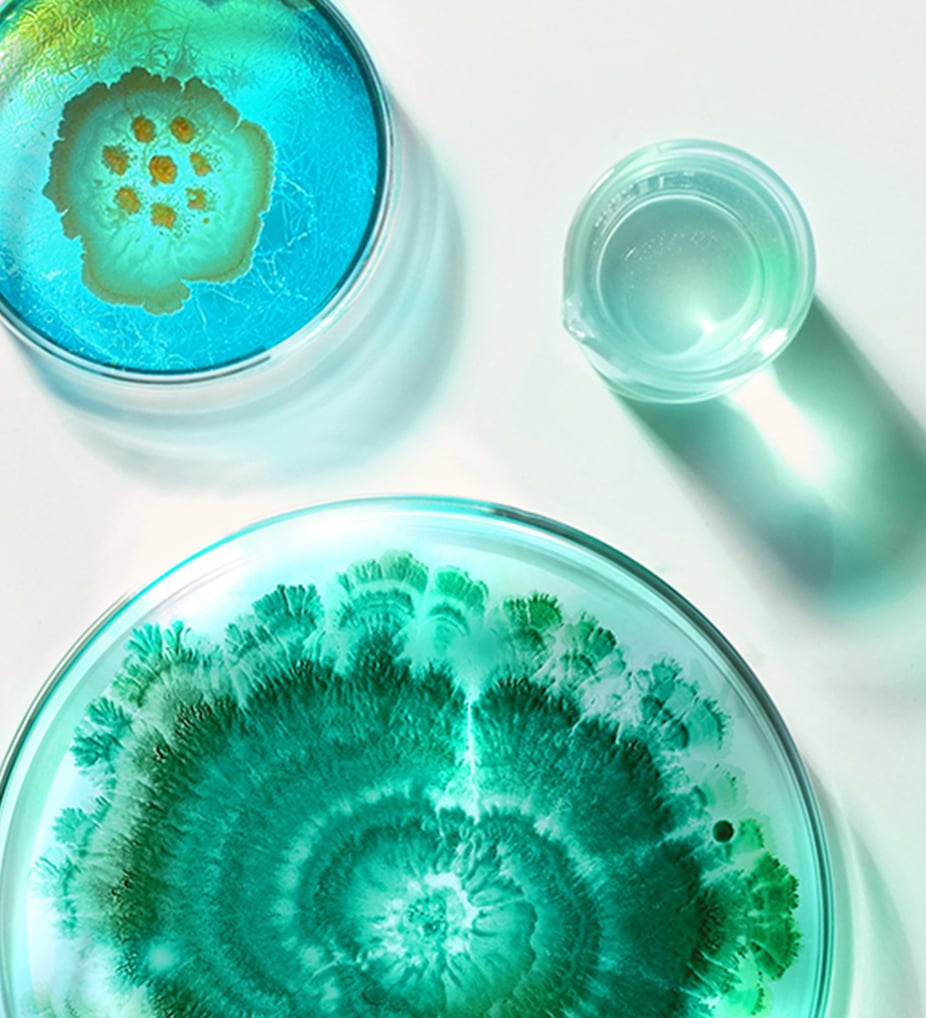

Mikrobiomet: hudens osynliga ekosystem – och hur du tar hand om det

Denna artikel är ett kommersiellt samarbete med Esse Skincare.
Mikrobiom, probiotika och prebiotika – vad är det? Och hur hänger det ihop med huden? Här får du lära dig om hudens osynliga ekosystem och om invånarna som bor på din hud! Vilka är de? Vad gör de? Vad äter de? Läs vidare för att ta reda på svaren!
Först och främst, vad är mikrobiom?
Kanske har du någon gång hört talas om tarmens mikrobiom och de goda bakterierna och mikroorganismerna som bor där? Men vad har det med huden att göra? Jo, faktum är att huden också har ett mikrobiom, eller hudflora eller mikrobiota som det även kallas (kärt barn har många namn).
På din hud lever massor av goda bakterier, jästsvampar och andra mikroorganismer som i ett osynligt ekosystem. Detta gäng bildar tillsammans hudens mikrobiom och fungerar som en skyddande barriär. Hos en frisk hud har man sett en hög mångfald i mikrobiomet. Huden och hudens mikrobiom är del av vårt yttre immunförsvar som skyddar oss mot patogener (patogener är de bakterier, virus, svampar och parasiter som kan orsaka sjukdom hos oss människor). Japp, det finns alltså både “goda” och “onda” bakterier.
Visste du att…Vid hudproblem som akne, eksem, och rosacea (som för övrigt är några av vår tids vanligaste hudproblem) verkar just hudens mikrobiom vara i obalans, alltså att någon eller några bakterier har tagit över. Om obalans i mikrobiomet är orsaken till hudproblemen, eller om det är symptom på något annat, verkar forskarna dock inte vara helt säkra på ännu, där krävs helt enkelt mer forskning.
Probiotika och prebiotika, vad är det?
När man pratar om hudens mikrobiom, finns det några begrepp som brukar komma upp – probiotika och prebiotika. Låt oss reda ut vad det är!
Probiotika – kallas de goda bakterier och mikroorganismer som lever på huden, som tillsammans utgör hudens mikrobiom.
Prebiotika – kan förenklat beskrivas som “mat” till de goda bakterierna och mikroorganismerna, så att de kan frodas och blomstra på huden. Inulin och Alpha-Glucan Oligosaccharides är två exempel på prebiotika som används i hudvård.
Har du koll på.. Att hudflorans sammansättning verkar vara beroende av den biologiska mångfalden i naturen där vi bor? Det finns studier som visat att hudens mikrobiom har större mångfald hos personer som bor nära naturen med skog och jordbruk omkring sig, jämfört med personer som bor i städer och nära vatten. En möjlig förklaring kan vara att vi (och immunförsvaret) exponeras för en större mångfald av mikroorganismer och bakterier i naturen, jämfört med i stan.
Esse Skincare – ekologisk och probiotisk hudvård
Ett hudvårdsvarumärke som djupdykt i hudens mikrobiom (bokstavligt talat) är Esse Skincare. De erbjuder ekologisk hudvård med probiotika, prebiotika och aktiva ingredienser, med syfte att stötta hudens mikrobiom – för en god hudhälsa och balanserad hudbarriär helt enkelt. Genom att stötta mikrobiomet får du en bättre barriärfunktion som stärker huden vilket kan minimera synligheten av ålderstecken, det kan även motverka uppkomsten av inflammatoriska tillstånd i huden.
Hudvård för olika behov
Esse Skincare har hudvårdsprodukter som passar olika hudtyper och hudtillstånd, som torr och känslig hud, oljig och kombinerad hud, normal eller mogen hud. Två produkter som passar alla hudtyper, och som kan kombineras med Esse Skincares övriga produkter, är Esse Skincare Probiotic Serum och Esse Skincare Sensitive Protect Oil.
Esse Skincare Probiotic Serum
- Probiotiskt serum med levande probiotika
- Stärker hudbarriären och ger en balanserad hud
- Huden känns mjukare och mera återfuktad direkt och långsiktigt

Esse Skincare
Probiotic Serum 30 ml
Använd såhär:
Detta serum med levande probiotika innehåller mer än en miljard levande probiotika (goda bakterier) per ml. Serumet passar utmärkt för daglig användning i din hudvårdsritual på morgonen, eller både morgon och kväll under en period när huden känns obalanserad. Probiotic Serum kommer bäst till sin rätt efter 2 veckors användning av Esse Skincare.
Esse Skincare Sensitive Protect Oil
- Lättabsorberad ansiktsolja
- Stärker barriärfunktionen och ger näring till huden
- Ger en härlig lyster och skön känsla på huden

Esse Skincare
Sensitive Protect Oil 15 ml
Använd såhär:
Denna närande olja är perfekt att använda i din hudvårdsritual till kvällen, för att binda fukt i huden, och stärka hudens barriärfunktion.
Tips för att ta hand om hudens mikrobiom
Använd milda produkter, speciellt rengöringar kan vara uttorkande och irritera hudbarriären. Vissa rengöringar tvättar inte bara bort de “onda” bakterierna, utan riskerar även att tvätta bort de “goda” – som vi ju vill ha kvar på huden!
Esse Skincare har hudvårdsprodukter för olika hudtyper och behov. Är du osäker på vad du har för hudtyp och vilka produkter som passar dig? Du kan alltid kontakta våra hudterapeuter här på Apohem för att få tips och råd.
Använd hudvårdsprodukter som innehåller ingredienser som stöttar hudens mikrobiom. Om det står inulin, oligosackarider och xylitol i ingredienslistan så vet du att produkten innehåller prebiotika.
Att tvätta huden med för hett vatten kan torka ut hudens naturliga oljor. Huden mår bättre av ljummet eller kallt vatten vid rengöring. Visst är det härligt med varmt vatten, men det kan vara påfrestande för den ömtåliga huden.
Om Esse Skincare
Esse Skincare grundades i Sydafrika 2002 av kemisten Trevor Steyn, och är ett vetenskapligt och resultatinriktat varumärke med ekologisk och probiotisk hudvård för alla hudtyper. Esse Skincares ingrediensval och produktframställning baseras på vetenskapliga studier. De testar sina produkter på oberoende laboratorium i Tyskland och är certifierade: ekologiskt, veganskt, koldioxidneutralt, plastneutralt, och testar inte på djur.

Isabelle skriver om allt från apotek, hälsa och skönhet för Magazine by Apohem. Hon kan guida inom allt från K-beauty till hur du tar hand om dina fyrbenta vänner. Alltid i tätt samarbete med Apohems egna hudterapeuter, farmaceuter och andra experter.